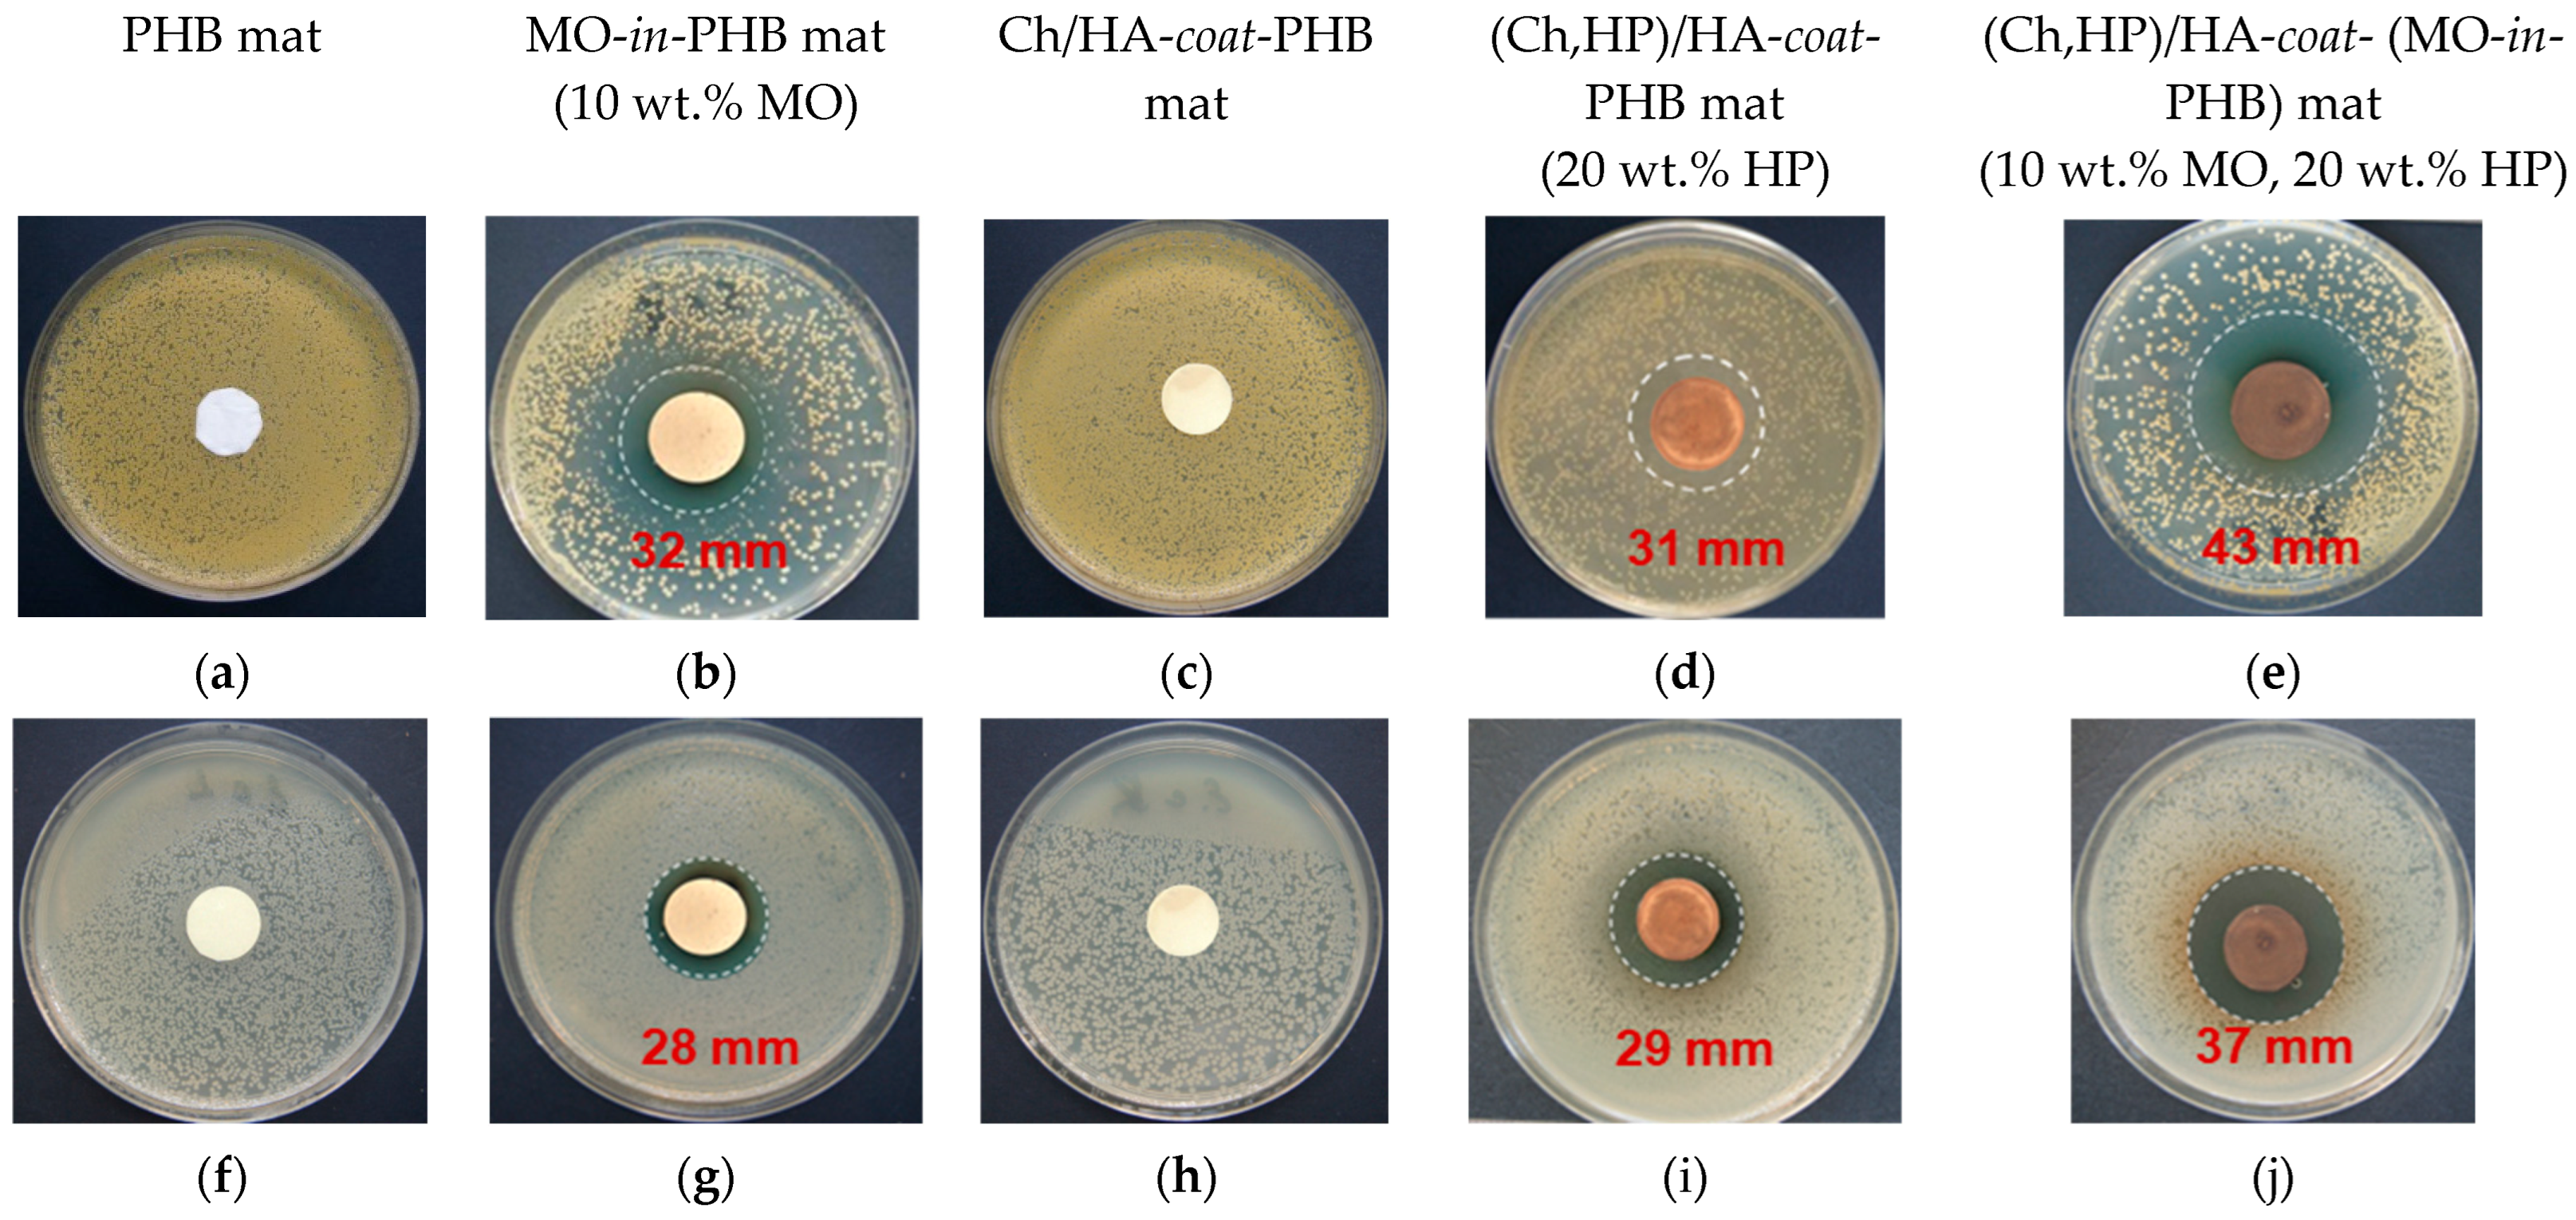
Polymers 16 02105 g008

Chitosan/Hyaluronate Complex-Coated Electrospun Poly(3-hydroxybutyrate) Materials Containing Extracts from Melissa officinalis and/or Hypericum perforatum with Various Biological Activities: Antioxidant, Antibacterial and In Vitro Anticancer Effects
Abstract
1. Introduction
2. Materials and Methods
2.1. Materials
2.2. Extraction of Plant Material
2.2.1. Extraction of MO
2.2.2. Extraction of HP
2.3. Characterization and Quantification of Dry Extracts of MO and HP by HPLC-DAD-ESI/MS
2.3.1. Characterization of Dry Extracts of MO and HP by HPLC-DAD-ESI/MS
2.3.2. Quantification of Rosmarinic Acid in MO Extract
2.3.3. Quantification of the Compounds in HP Extract
2.3.4. Isolation of I3,II-biapigenin and Hyperforin
2.4. Preparation of the Fibrous Mats
2.4.1. Preparation of Neat and MO-Containing PHB Mats by Electrospinning
2.4.2. Preparation of Ch/HA-coat-PHB Mats by Electrospinning, Dip Coating, and PEC Formation
2.4.3. Preparation of (Ch,HP)/HA-coat-PHB and (Ch,HP)/HA-coat-(MO-in-PHB) Mats by Electrospinning, Dip Coating, and PEC Formation
2.5. Fibrous Mats Characterization
2.6. In Vitro Release Studies
2.7. Antioxidant Activity of the Mats
2.8. Microbiological Tests against S. aureus and E. coli
2.9. Evaluation of the In Vitro Anticancer Activity
2.9.1. Cell Culturing
2.9.2. Cytotoxicity Assay
2.9.3. Cytomorphological Fluorescence Microscopy Analyses
2.10. Statistical Analysis
3. Results and Discussion
3.1. Phytochemical Characterization of MO and HP Dry Extracts by HPLC-DAD-ESI/MS
3.1.1. Phytochemical Characterization of MO Dry Extract
3.1.2. Phytochemical Characterization of HP Extract
3.2. Preparation and Morphology of the Fibrous Mats
3.3. Wettability of the Mats
3.4. ATR–FTIR Spectroscopy of the Mats
3.5. XRD Analysis of the Mats
3.6. Thermal Behavior of the Mats
3.7. In Vitro Release Studies
3.8. Antioxidant Properties of the Mats
3.9. Antibacterial Activity of the Fibrous Mats
3.10. Evaluation of the Effect of the Fibrous Mats on the Viability of HeLa and BALB/3T3 Cells Using an MTT Assay
3.11. Fluorescence Microscopy Analysis of Cell Death
4. Conclusions
Supplementary Materials
Author Contributions
Funding
Institutional Review Board Statement
Data Availability Statement
Acknowledgments
Conflicts of Interest
References
- Wang, C.; Wang, J.; Zeng, L.; Qiao, Z.; Liu, X.; Liu, H.; Zhang, J.; Ding, J. Fabrication of Electrospun Polymer Nanofibers with Diverse Morphologies. Molecules 2019, 24, 834. [Google Scholar] [CrossRef]
- Xue, J.; Wu, T.; Dai, Y.; Xia, Y. Electrospinning and Electrospun Nanofibers: Methods, Materials, and Applications. Chem. Rev. 2019, 119, 5298–5415. [Google Scholar] [CrossRef] [PubMed]
- Kuang, G.; Lin, X.; Li, J.; Sun, W.; Zhang, Q.; Zhao, Y. Electrospun nanofibers-derived functional scaffolds for cancer therapy. J. Chem. Eng. 2024, 489, 151253. [Google Scholar] [CrossRef]
- Yang, Y.; Du, Y.; Zhang, J.; Zhang, H.; Guo, B. Structural and Functional Design of Electrospun Nanofibers for Hemostasis and Wound Healing. Adv. Fiber Mater. 2022, 4, 1027–1057. [Google Scholar] [CrossRef]
- Rahmati, M.; Mills, D.; Urbanska, A.; Saeb, M.; Venugopal, J.; Ramakrishna, S.; Mozafari, M. Electrospinning for tissue engineering applications. Prog. Mater. Sci. 2021, 117, 100721. [Google Scholar] [CrossRef]
- Cheng, H.; Yang, X.; Che, X.; Yang, M.; Zhai, G. Biomedical application and controlled drug release of electrospun fibrous materials. Mater. Sci. Eng. C 2018, 90, 750–763. [Google Scholar] [CrossRef]
- Ali, A.Q.; Kannan, T.P.; Ahmad, A.; Samsudin, A.R. In vitro genotoxicity tests for polyhydroxybutyrate—A synthetic biomaterial. Toxicol. In Vitro 2008, 22, 57–67. [Google Scholar] [CrossRef] [PubMed]
- Carswell-Pomerantz, T.; Hill, D.J.T.; O’Donnell, J.H.; Pomery, P.J. An electro spin resonance study of the radiation chemistry of poly(hydroxybutyrate). Radiat. Phys. Chem. 1995, 45, 737–744. [Google Scholar] [CrossRef]
- Wang, C.; Hsu, C.-H.; Hwang, I.-H. Scaling laws and internal structure for characterizing electrospun poly[(R)-3-hydroxybutyrate] fibers. Polymer 2008, 49, 4188–4195. [Google Scholar] [CrossRef]
- Correia, D.M.; Ribeiro, C.; Ferreira, J.C.C.; Botelho, G.; Gómez Ribelles, J.L.; Lanceros Mendez, S.; Sencadas, V. Influence of electrospinning parameters on poly(hydroxybutyrate) electrospun membranes fiber size and distribution. Polym. Eng. Sci. 2014, 54, 1608–1617. [Google Scholar] [CrossRef]
- Fraser, J.R.; Laurent, T.C.; Laurent, U.B. Hyaluronan: Its nature, distribution, functions and turnover. J. Intern. Med. 1997, 242, 27–33. [Google Scholar] [CrossRef]
- Romanò, C.L.; De Vecchi, E.; Bortolin, M.; Morelli, I.; Drago, L. Hyaluronic acid and its composites as a local antimicrobial/antiadhesive barrier. J. Bone Jt. Infect. 2017, 2, 63–72. [Google Scholar] [CrossRef] [PubMed]
- Bukhari, S.N.A.; Roswandi, N.L.; Waqas, M.; Habib, H.; Hussain, F.; Khan, S.; Muhammad, S.; Ramli, N.A.; Thu, H.N.; Hussain, Z. Hyaluronic acid, a promising skin rejuvenating biomedicine: A review of recent updates and pre-clinical and clinical investigations on cosmetic and nutricosmetic effects. Int. J. Biol. Macromol. 2018, 120, 1682–1695. [Google Scholar] [CrossRef]
- Volpi, N.; Schiller, J.; Stern, R.; Šoltés, L. Role, metabolism, chemical modifications and applications of hyaluronan. Curr. Med. Chem. 2009, 16, 1718–1745. [Google Scholar] [CrossRef] [PubMed]
- Rinaudo, M. Chitin and chitosan: Properties and applications. Prog. Polym. Sci. 2006, 31, 603–632. [Google Scholar] [CrossRef]
- Liu, X.F.; Guan, Y.L.; Yang, D.Z.; Li, Z.; De Yao, K. Antibacterial action of chitosan and carboxymethylated chitosan. J. Appl. Polym. Sci. 2000, 79, 1324–1335. [Google Scholar]
- Qin, C.; Du, Y.; Xiao, L.; Li, Z.; Gao, X. Enzymic preparation of water-soluble chitosan and their antitumor activity. Int. J. Biol. Macromol. 2002, 31, 111–117. [Google Scholar] [CrossRef]
- Kayitmazer, A.B.; Koksal, A.F.; Kilic Iyilik, E. Complex coacervation of hyaluronic acid and chitosan: Effects of pH, ionic strength, charge density, chain length and the charge ratio. Soft Matter 2015, 11, 8605–8612. [Google Scholar] [CrossRef] [PubMed]
- Hamman, J.H. Chitosan Based Polyelectrolyte Complexes as Potential Carrier Materials in Drug Delivery Systems. Mar. Drugs 2010, 8, 1305–1322. [Google Scholar] [CrossRef]
- Yudaev, P.A.; Evgeniy, M.; Chistyakov, E.M. Progress in dental materials: Application of natural ingredients. Russ. Chem. Rev. 2024, 93, 1–19. [Google Scholar] [CrossRef]
- Chaachouay, N.; Zidane, L. Plant-Derived Natural Products: A Source for Drug Discovery and Development. Drugs Drug Candidates 2024, 3, 184–207. [Google Scholar] [CrossRef]
- Petrisor, G.; Motelica, L.; Craciun, L.N.; Oprea, O.C.; Ficai, D.; Ficai, A. Melissa officinalis: Composition, Pharmacological Effects and Derived Release Systems—A Review. Int. J. Mol. Sci. 2022, 23, 3591. [Google Scholar] [CrossRef] [PubMed]
- Hassan, R.A.; Abotaleb, S.T.; Hamed, H.B.; Eldeen, M.S. Antioxidant and Antimicrobial Activities of Melissa officinalis L. (Lemon Balm) Extracts. J. Agric. Chem. Biotechnol. 2019, 10, 183–187. [Google Scholar] [CrossRef]
- Araújo, S.G.; Lima, W.G.; Pinto, M.E.A.; Morais, M.; de Sá, N.P.; Johann, S.; Rosa, C.A.; Lima, L.A.R.D.S. Pharmacological prospection in-vitro of Lamiaceae species against human pathogenic fungi associated to invasive infections. Biocatal. Agric. Biotechnol. 2019, 21, 101345. [Google Scholar] [CrossRef]
- Cenić Milošević, D.; Tambur, Z.; Bokonjić, D.; Ivančajić, S.; Stanojković, T.; Grozdanić, N.; Juranić, Z. Antiproliferative effects of some medicinal plants on HeLa cells. Arch. Biol. Sci. 2013, 65, 65–70. [Google Scholar] [CrossRef]
- Koksal, E.; Bursal, E.; Dikici, E.; Tozoglu, F.; Gulcin, I. Antioxidant activity of Melissa officinalis leaves. J. Med. Plant Res. 2011, 5, 217–222. [Google Scholar]
- Astani, A.; Reichling, J.; Schnitzler, P. Melissa officinalis Extract Inhibits Attachment of Herpes Simplex Virus in vitro. Chemotherapy 2012, 58, 70–77. [Google Scholar] [CrossRef]
- Ghiulai, R.; Avram, S.; Stoian, D.; Pavel, I.Z.; Coricovac, D.; Oprean, C.; Vlase, L.; Farcas, C.; Mioc, M.; Minda, D.; et al. Lemon Balm Extracts Prevent Breast Cancer Progression In Vitro and In Ovo on Chorioallantoic Membrane Assay. Evid.-Based Complement. Alternat. Med. 2020, 2020, 6489159. [Google Scholar] [CrossRef]
- Ghazizadeh, J.; Hamedeyazdan, S.; Torbati, M.; Farajdokht, F.; Fakhari, A.; Mahmoudi, J.; Araj-khodaei, M.; Sadigh-Eteghad, S. Melissa officinalis L. hydro-alcoholic extract inhibits anxiety and depression through prevention of central oxidative stress and apoptosis. Exp. Physiol. 2020, 105, 707–720. [Google Scholar] [CrossRef]
- Gürbüz, P.; Martinez, A.; Pérez, C.; Martínez-González, L.; Göger, F.; Ayran, I. Potential anti-Alzheimer effects of selected Lamiaceae plants through polypharmacology on glycogen synthase kinase-3β, β-secretase, and casein kinase 1δ. Ind. Crop. Prod. 2019, 138, 111431. [Google Scholar] [CrossRef]
- Bayat, M.; Tameh, A.A.; Ghahremani, M.H.; Akbari, M.; Mehr, S.E.; Khanavi, M.; Hassanzadeh, G. Neuroprotective properties of Melissa officinalis after hypoxic-ischemic injury both in vitro and in vivo. DARU J. Pharm. Sci. 2012, 20, 42. [Google Scholar] [CrossRef] [PubMed]
- Sedighi, M.; Faghihi, M.; Rafieian-Kopaei, M.; Rasoulian, B.; Nazari, A. Cardioprotective effect of ethanolic leaf extract of Melissa officinalis L. against regional ischemia-induced arrhythmia and heart injury after five days of reperfusion in rats. Iran. J. Pharm. Res. 2019, 18, 1530–1542. [Google Scholar] [PubMed]
- Kholghi, G.; Arjmandi-Rad, S.; Zarrindast, M.-R.; Vaseghi, S. St. John’s wort (Hypericum perforatum) and depression: What happens to the neurotransmitter systems? Naunyn Schmiedebergs Arch. Pharmacol. 2022, 395, 629–642. [Google Scholar] [CrossRef] [PubMed]
- Saddiqe, Z.; Naeem, I.; Maimoona, A. A review of the antibacterial activity of Hypericum perforatum L. J. Ethnopharmacol. 2010, 131, 511–521. [Google Scholar] [CrossRef] [PubMed]
- Milosevic, T.; Solujic, S.; Sukdolak, S. In Vitro Study of Ethanolic Extract of Hypericum perforatum L. on Growth and Sporulation of Some Bacteria and Fungi. Turk. J. Biol. 2007, 31, 237–241. [Google Scholar]
- Kavurmacı, R.; Yalcin, S. Evaluation of In Vitro Anti-Proliferative Activity of St. John’s Wort (Hypericum perforatum Linn.) Plant Extract on Cervix Adenocarcinoma. Proceedings 2017, 1, 1037. [Google Scholar] [CrossRef]
- Seyrekoglu, F.; Temiz, H.; Eser, F.; Yildirim, C. Comparison of the antioxidant activities and major constituents of three Hypericum species (H. perforatum, H. scabrum and H. origanifolium) from Turkey. S. Afr. J. Bot. 2022, 146, 723–727. [Google Scholar] [CrossRef]
- Raak, C.; Büssing, A.; Gassmann, G.; Boehm, K.; Ostermann, T. A systematic review and meta-analysis on the use of Hypericum perforatum (St. John’s Wort) for pain conditions in dental practice. Homeopathy 2012, 101, 204–210. [Google Scholar] [PubMed]
- Chen, H.; Muhammad, I.; Zhang, Y.; Ren, Y.; Zhang, R.; Huang, X.; Diao, L.; Liu, H.; Li, X.; Sun, X.; et al. Antiviral activity against infectious bronchitis virus and bioactive components of Hypericum perforatum L. Front. Pharmacol. 2019, 10, 1272. [Google Scholar] [CrossRef]
- Dikmen, M.; Öztürk, Y.; Sagratini, G.; Ricciutelli, M.; Vittori, S.; Maggi, F. Evaluation of the wound healing potentials of two subspecies of Hypericum perforatum on cultured NIH3T3 fibroblasts. Phyther. Res. 2010, 25, 208–214. [Google Scholar] [CrossRef]
- Stoyanova, N.; Spasova, M.; Manolova, N.; Rashkov, I.; Kamenova-Nacheva, M.; Staleva, P.; Tavlinova-Kirilova, M. Electrospun PLA-Based Biomaterials Loaded with Melissa officinalis Extract with Strong Antioxidant Activity. Polymers 2023, 15, 1070. [Google Scholar] [CrossRef] [PubMed]
- Râpa, M.; Gaidau, C.; Mititelu-Tartau, L.; Berechet, M.-D.; Berbecaru, A.C.; Rosca, I.; Chiriac, A.P.; Matei, E.; Predescu, A.-M.; Predescu, C. Bioactive Collagen Hydrolysate-Chitosan/Essential Oil Electrospun Nanofibers Designed for Medical Wound Dressings. Pharmaceutics 2021, 13, 1939. [Google Scholar] [CrossRef] [PubMed]
- Avci, H.; Gergeroglu, H. Synergistic effects of plant extracts and polymers on structural and antibacterial properties for wound healing. Polym. Bull. 2019, 76, 3709–3731. [Google Scholar] [CrossRef]
- Pourhojat, F.; Shariati, S.; Sohrabi, M.; Mahdavi, H.; Asadpour, L. Preparation of antibacterial electrospun Polylactic-co–glycolic acid nanofibers containing Hypericum perforatum with bedsore healing property and evaluation of its drug release performance. Int. J. Nano Dimens. 2018, 9, 286–297. [Google Scholar]
- Pourhojat, F.; Sohrabi, M.; Shariati, S.; Mahdavi, H.; Asadpour, L. Evaluation of poly ε-caprolactone electrospun nanofibers loaded with Hypericum perforatum extract as a wound dressing. Res. Chem. Intermed. 2017, 43, 297–320. [Google Scholar] [CrossRef]
- García-Hernández, A.; Morales-Sánchez, E.; Berdeja-Martínez, B.; Escamilla-García, M.; Salgado-Cruz, M.P.; Rentería-Ortega, M.; Farrera-Rebollo, R.R.; Vega-Cuellar, M.; Calderón-Domínguez, G. PVA-Based Electrospun Biomembranes with Hydrolyzed Collagen and Ethanolic Extract of Hypericum perforatum for Potential Use as Wound Dressing: Fabrication and Characterization. Polymers 2022, 14, 1981. [Google Scholar] [CrossRef] [PubMed]
- Erdoğmuş, S.F.; Altintaş, Ö.E.; Demirel, H.H.; Okumuş, N. Fabrication of wound dressings: Herbal extract-loaded nanoliposomes embedded in fungal chitosan/polycaprolactone electrospun nanofibers for tissue regeneration. Microsc. Res. Tech. 2024, 87, 360–372. [Google Scholar] [CrossRef] [PubMed]
- Mouro, C.; Gomes, A.P.; Gouveia, I.C. Double-Layer PLLA/PEO_chitosan Nanofibrous Mats Containing Hypericum perforatum L. As an Effective Approach for Wound Treatment. Polym. Adv. Technol. 2020, 32, 1493–1506. [Google Scholar] [CrossRef]
- Beran, M.; Horna, A.; Vorisek, V.; Berkova, E.; Korinkova, R.; Trousil, V.; Hrubanova, M. Antimicrobial Polyhydroxybutyrate Submicron Fiber Mat Loaded with Extract of Hypericum perforatum. J. Plant Biotechnol. 2022, 49, 257–270. [Google Scholar] [CrossRef]
- Mouro, C.; Gomes, A.P.; Gouveia, I.C. Emulsion Electrospinning of PLLA/PVA/Chitosan with Hypericum perforatum L. as an Antibacterial Nanofibrous Wound Dressing. Gels 2023, 9, 353. [Google Scholar] [CrossRef]
- Zeliou, K.; Kontaxis, N.I.; Margianni, E.; Petrou, C.; Lamari, F.N. Optimized and Validated HPLC Analysis of St. John’s Wort Extract and Final Products by Simultaneous Determination of Major Ingredients. J. Chromatogr. Sci. 2017, 55, 805–812. [Google Scholar] [CrossRef] [PubMed]
- Adam, P.; Arigoni, D.; Bacher, A.; Eisenreich, W. Biosynthesis of Hyperforin in Hypericum perforatum. J. Med. Chem. 2002, 45, 4786–4793. [Google Scholar] [CrossRef] [PubMed]
- Berghöfer, R.; Hölzl, J. Biflavonoids in Hypericum perforatum 1; Part 1. Isolation of I3, II8-Biapigenin. Planta Medica 1987, 53, 216–217. [Google Scholar] [CrossRef] [PubMed]
- St. John’s wort dry extract, quantified. In European Pharmacopoeia 9.0, 9th ed.; Council of Europe: Strasbourg, France, 2017; pp. 1527–1529.
- Luppi, B.; Bigucci, F.; Mercolini, L.; Musenga, A.; Sorrenti, M.; Catenacci, L.; Zecchi, V. Novel mucoadhesive nasal inserts based on chitosan/hyaluronate polyelectrolyte complexes for peptide and protein delivery. J. Pharm. Pharmacol. 2009, 61, 151–157. [Google Scholar] [CrossRef]
- Vaarum, K.M.; Smidsrod, O. Structure–property relationship in chitosans. In Polysaccharides: Structural Diversity and Functional Versatility; Dumitriu, S., Ed.; Marcel Dekker Inc.: New York, NY, USA, 2005; pp. 625–660. [Google Scholar]
- Kim, C.H.; Khil, M.S.; Kim, H.Y.; Lee, H.U.; Jahng, K.Y. An improved hydrophilicity via electrospinning for enhanced cell attachment and proliferation. J. Biomed. Mater. Res. B Appl. Biomater. 2006, 78, 283–290. [Google Scholar] [CrossRef] [PubMed]
- Nayeri, F.; Mafakheri, S.; Mirhosseini, M.; Sayyed, R. Phyto-mediated silver nanoparticles via Melissa officinalis aqueous and methanolic extracts: Synthesis, characterization and biological properties against infectious bacterial strains. Int. J. Adv. Biol. Biomed. Res. 2021, 9, 270–285. [Google Scholar]
- Sipos, S.; Moacă, E.-A.; Pavel, I.Z.; Avram, S.; Creţu, O.M.; Coricovac, D.; Racoviceanu, R.-M.; Ghiulai, R.; Pană, R.D.; Şoica, C.M.; et al. Melissa officinalis L. Aqueous Extract Exerts Antioxidant and Antiangiogenic Effects and Improves Physiological Skin Parameters. Molecules 2021, 26, 2369. [Google Scholar] [CrossRef] [PubMed]
- Pradhan, S.; Dikshit, P.K.; Moholkar, V.S. Production, ultrasonic extraction, and characterization of poly (3-hydroxybutyrate) (PHB) using Bacillus megaterium and Cupriavidus necator. Polym. Advan. Technol. 2018, 29, 2392–2400. [Google Scholar] [CrossRef]
- Barroso, N.; Guaresti, O.; Pérez-Álvarez, L.; Ruiz-Rubio, L.; Gabilondo, N.; Vilas-Vilela, J.L. Self-healable hyaluronic acid/chitosan polyelectrolyte complex hydrogels and multilayers. Eur. Polym. J. 2019, 120, 109268. [Google Scholar] [CrossRef]
- Vatankhah, E. Rosmarinic acid-loaded electrospun nanofibers: In vitro release kinetic study and bioactivity assessment. Eng. Life Sci. 2018, 18, 732–742. [Google Scholar] [CrossRef]
- Schiera, V.; Pavia, F.C.; Carrubba, V.; Brucato, V.; Dintcheva, N.T. Poly-L-Lactic Acid Scaffolds Additivated with Rosmarinic Acid: A Multi-Analytical Approach to Assess The Morphology, Thermal Behavior, and Hydrophilicity. Polymers 2024, 16, 1672. [Google Scholar] [CrossRef]
- Kim, S.J.; Shin, S.R.; Lee, S.M.; Kim, I.Y.; Kim, S.I. Thermal Characteristics of Polyelectrolyte Complexes Composed of Chitosan and Hyaluronic Acid. J. Macromol. Sci. A Pure Appl. Chem. 2003, 40, 807–815. [Google Scholar] [CrossRef]
- Carneiro-da-Cunha, M.G.; Cerqueira, M.A.; Souza, B.W.S.; Carvalho, S.; Quintas, M.A.C.; Teixeira, J.A.; Vicente, A.A. Physical and thermal properties of a chitosan/alginate nanolayered PET film. Carbohydr. Polym. 2010, 82, 153–159. [Google Scholar] [CrossRef]
- Ignatova, M.G.; Manolova, N.E.; Rashkov, I.B.; Markova, N.D.; Toshkova, R.A.; Georgieva, A.K.; Nikolova, E.B. Poly(3-hydroxybutyrate)/caffeic acid electrospun fibrous materials coated with polyelectrolyte complex and their antibacterial activity and in vitro antitumor effect against HeLa cells. Mater. Sci. Eng. C 2016, 65, 379–392. [Google Scholar] [CrossRef]
- Kamburova, K.; Mitarova, K.; Radeva, T. Polysaccharide-based nanocapsules for controlled release of indomethacin. Colloids Surf. A Physicochem. Eng. Asp. 2017, 519, 199–204. [Google Scholar] [CrossRef]
- Mohammed, A.A.; Niamah, A.K. Identification and antioxidant activity of hyaluronic acid extracted from local isolates of Streptococcus thermophiles. Mater. Today Proc. 2022, 60, 1523–1529. [Google Scholar] [CrossRef]
- Kuppusamy, S.K.; Karuppaiah, J. In Vitro evaluation of free radical scavenging activity of chitosan. IJPLS 2013, 4, 2685–2690. [Google Scholar]
- Costerton, J.W.; Cheng, K.-J. The role of the bacterial cell envelope in antibiotic resistance. J. Antimicrob. Chemother. 1975, 1, 363–377. [Google Scholar] [CrossRef]
- Costerton, J.W.; Irvin, R.T.; Cheng, K.-J. The role of bacterial surface structures in pathogenesis. Crit. Rev. Microbiol. 1981, 8, 303–338. [Google Scholar] [CrossRef]
- Imamović, B.; Komlen, V.; Gavrić, T.; Sunulahpašić, A.; Lalević, B.; Hamidović, S. Antimicrobial activity of ginger (Zingiber officinale) and rosemary (Rosmarinus officinalis) essential oils. Agric. For. 2021, 67, 231–238. [Google Scholar] [CrossRef]
- Yu, H.; Pei, J.; Qiu, W.; Mei, J.; Xie, J. The Antimicrobial Effect of Melissa officinalis L. Essential Oil on Vibrio parahaemolyticus: Insights Based on the Cell Membrane and External Structure. Front. Microbiol. 2022, 13, 812792. [Google Scholar] [CrossRef]
- Sherif, M.M.; Elshikh, H.H.; Abdel-Aziz, M.M.; Elaasser, M.M.; Yosri, M. In Vitro Antibacterial and Phytochemical Screening of Hypericum perforatum Extract as Potential Antimicrobial Agents against Multi-Drug-Resistant (MDR) Strains of Clinical Origin. Biomed. Res. Int. 2023, 2023, 6934398. [Google Scholar] [CrossRef]
- Tacar, O.; Sriamornsak, P.; Dass, C.R. Doxorubicin: An update on anticancer molecular action, toxicity and novel drug delivery systems. J. Pharm. Pharmacol. 2013, 65, 157–170. [Google Scholar] [CrossRef] [PubMed]
- Matić, I.Z.; Ergün, S.; Crnogorac, M.Đ.; Misir, S.; Aliyazicioğlu, Y.; Damjanović, A.; Džudžević-Čančar, H.; Stanojković, T.; Konanç, K.; Petrović, N. Cytotoxic activities of Hypericum perforatum L. extracts against 2D and 3D cancer cell models. Cytotechnology 2021, 73, 373–389. [Google Scholar] [CrossRef]
- Moacă, E.A.; Farcaş, C.; Ghiţu, A.; Coricovac, D.; Popovici, R.; Cărăba-Meiţă, N.L.; Ardelean, F.; Antal, D.S.; Dehelean, C.; Avram, Ş. A comparative study of Melissa officinalis leaves and stems ethanolic extracts in terms of antioxidant, cytotoxic, and antiproliferative potential. Evid. Based Complement. Alternat. Med. 2018, 2018, 7860456. [Google Scholar] [CrossRef]
- Skalkos, D.; Gioti, E.; Stalikas, C.D.; Meyer, H.; Papazoglou, T.G.; Filippidis, G. Photophysical properties of Hypericum perforatum L. extracts–Novel photosensitizers for PDT. J. Photochem. Photobiol. B Biol. 2006, 82, 146–151. [Google Scholar] [CrossRef]
- Theodossiou, T.A.; Hothersall, J.S.; De Witte, P.A.; Pantos, A.; Agostinis, P. The multifaceted photocytotoxic profile of hypericin. Mol. Pharm. 2009, 6, 1775–1789. [Google Scholar] [CrossRef]
- Kubin, A.; Loew, H.G.; Burner, U.; Jessner, G.; Kolbabek, H.; Wierrani, F. How to make hypericin water-soluble. Pharmazie 2008, 63, 263–269. [Google Scholar]
- Sgarbossa, A.; Buselli, D.; Lenci, F. In vitro perturbation of aggregation processes in beta-amyloid peptides: A spectroscopic study. FEBS Lett. 2008, 582, 3288–3292. [Google Scholar] [CrossRef]
- Kakouri, E.; Trigas, P.; Daferera, D.; Skotti, E.; Tarantilis, P.A.; Kanakis, C. Chemical characterization and antioxidant activity of nine Hypericum species from Greece. Antioxidants 2023, 12, 899. [Google Scholar] [CrossRef]
- Sakavitsi, M.E.; Christodoulou, M.I.; Tchoumtchoua, J.; Fokialakis, N.; Kokkinopoulou, I.K.; Papageorgiou, E.; Argyropoulou, A.; Skaltsounis, L.A.; Halabalaki, M.; Scorilas, A. Comparative HPLC-DAD and UHPLC-ESI (-)-HRMS & MS/MS profiling of Hypericum species and correlation with necrotic cell-death activity in human leukemic cells. Phytochem. Let. 2017, 20, 481–490. [Google Scholar]
- Milevskaya, V.V.; Statkus, M.A.; Temerdashev, Z.A.; Kiseleva, N.V.; Butylskaya, T.S.; Shilko, E.A. Extraction and determination of biologically active components of St. John’s wort and its pharmaceutical preparations. J. Anal. Chem. 2016, 71, 741–747. [Google Scholar] [CrossRef]

| Fabricated Fibrous Mats | Components | |||
|---|---|---|---|---|
| PHB | MO | Ch/HA | Ch/HA Loaded with HP | |
| PHB | × | |||
| MO-in-PHB | × | × | ||
| Ch/HA-coat-PHB | × | × | ||
| Ch/HA-coat-(MO-in-PHB) | × | × | × | |
| (Ch,HP)/HA-coat-PHB | × | × | ||
| (Ch,HP)/HA-coat-(MO-in-PHB) | × | × | × | |
| Tested Compounds | 24 h | 72 h |
|---|---|---|
| MO | 163.2 | 141.6 |
| HP | 182.4 | 163.2 |
| DOX | 2.3 | 0.1 |
Disclaimer/Publisher’s Note: The statements, opinions and data contained in all publications are solely those of the individual author(s) and contributor(s) and not of MDPI and/or the editor(s). MDPI and/or the editor(s) disclaim responsibility for any injury to people or property resulting from any ideas, methods, instructions or products referred to in the content. |
© 2024 by the authors. Licensee MDPI, Basel, Switzerland. This article is an open access article distributed under the terms and conditions of the Creative Commons Attribution (CC BY) license (https://creativecommons.org/licenses/by/4.0/).
Share and Cite
Anastasova, I.; Ignatova, M.; Manolova, N.; Rashkov, I.; Markova, N.; Toshkova, R.; Georgieva, A.; Kamenova-Nacheva, M.; Trendafilova, A.; Ivanova, V.; et al. Chitosan/Hyaluronate Complex-Coated Electrospun Poly(3-hydroxybutyrate) Materials Containing Extracts from Melissa officinalis and/or Hypericum perforatum with Various Biological Activities: Antioxidant, Antibacterial and In Vitro Anticancer Effects. Polymers 2024, 16, 2105. https://doi.org/10.3390/polym16152105
Anastasova I, Ignatova M, Manolova N, Rashkov I, Markova N, Toshkova R, Georgieva A, Kamenova-Nacheva M, Trendafilova A, Ivanova V, et al. Chitosan/Hyaluronate Complex-Coated Electrospun Poly(3-hydroxybutyrate) Materials Containing Extracts from Melissa officinalis and/or Hypericum perforatum with Various Biological Activities: Antioxidant, Antibacterial and In Vitro Anticancer Effects. Polymers. 2024; 16(15):2105. https://doi.org/10.3390/polym16152105
Chicago/Turabian StyleAnastasova, Ina, Milena Ignatova, Nevena Manolova, Iliya Rashkov, Nadya Markova, Reneta Toshkova, Ani Georgieva, Mariana Kamenova-Nacheva, Antoaneta Trendafilova, Viktoria Ivanova, and et al. 2024. "Chitosan/Hyaluronate Complex-Coated Electrospun Poly(3-hydroxybutyrate) Materials Containing Extracts from Melissa officinalis and/or Hypericum perforatum with Various Biological Activities: Antioxidant, Antibacterial and In Vitro Anticancer Effects" Polymers 16, no. 15: 2105. https://doi.org/10.3390/polym16152105
APA StyleAnastasova, I., Ignatova, M., Manolova, N., Rashkov, I., Markova, N., Toshkova, R., Georgieva, A., Kamenova-Nacheva, M., Trendafilova, A., Ivanova, V., & Doncheva, T. (2024). Chitosan/Hyaluronate Complex-Coated Electrospun Poly(3-hydroxybutyrate) Materials Containing Extracts from Melissa officinalis and/or Hypericum perforatum with Various Biological Activities: Antioxidant, Antibacterial and In Vitro Anticancer Effects. Polymers, 16(15), 2105. https://doi.org/10.3390/polym16152105

